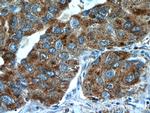
TUSC4 Antibody in Immunohistochemistry (Paraffin) (IHC (P))

Search
Proteintech
TUSC4 Polyclonal Antibody
{{$productOrderCtrl.translations['antibody.pdp.commerceCard.promotion.promotions']}}
{{$productOrderCtrl.translations['antibody.pdp.commerceCard.promotion.viewpromo']}}
{{$productOrderCtrl.translations['antibody.pdp.commerceCard.promotion.promocode']}}: {{promo.promoCode}} {{promo.promoTitle}} {{promo.promoDescription}}. {{$productOrderCtrl.translations['antibody.pdp.commerceCard.promotion.learnmore']}}
产品信息
10157-1-AP
种属反应
已发表种属
宿主/亚型
分类
类型
抗原
偶联物
形式
浓度
规格
纯化类型
保存液
内含物
保存条件
运输条件
产品详细信息
Immunogen sequence: GCRIECIFF SEFHPTLGPK ITYQVPEDFI SRELFDTVQV YIITKPELQN KLITVTAMEK KLIGCPVCIE HKKYSRNALL FNLGFVCDAQ AKTCALEPIV KKLAGYLTTL ELESSFVSME ESKQKLVPIM TILLEELNAS GRCTLPIDES NTIHLKVIEQ RPDPPVAQEY DVPVFTKDKE DFFNSQWDLT TQQILPYIDG FRHIQKISAE ADVELNLVRI AIQNLLYYGV VTLVSILQYS NVYCPTPKVQ DLVDDKSLQE ACLSYVTKQG H (1-270 aa encoded by BC002791)
靶标信息
NPRL2, also known as TUSC4 (tumor suppressor candidate 4), is a 380 amino acid protein that contains a bipartite nuclear localization signal and a granulin protein-binding domain. It is highly expressed in skeletal muscle, followed by brain, liver and pancreas, with lower expression in lung, kidney, placenta and heart. NPRL2 is also expressed in most lung cancer cell lines and may be involved in tumor suppression. NPRL2 may play a role in mismatch repair, cell cycle checkpoint signaling and activation of apoptotic pathways. It may also enhance the therapeutic efficacy of chemotherapy drugs such as cis-platin by resensitizing patients resistant to cisplatin treatment. The gene encoding NPRL2 is conserved between species and is expressed as two isoforms due to alternative splicing events.
仅用于科研。不用于诊断过程。未经明确授权不得转售。
生物信息学
蛋白别名: 2810446G01Rik; G21 protein; GATOR complex protein NPRL2; GATOR1 complex protein NPRL2; Gene 21 protein; homologous to yeast nitrogen permease (candidate tumor suppressor); mutant NPRL2; nitrogen permase homolog; Nitrogen permease regulator 2-like protein; NPR 2L; NPR L2; NPR like 2; NPR2 like; NPR2-like protein; NPRL 2; similar to yeast NPR2 nitrogen permease regulator; Tumor suppressor candidate 4; TUSC 4; TUSC 4 protein; TUSC4; TUSC4 protein; unnamed protein product
基因别名: 2810446G01Rik; FFEVF2; G21; NPR2; NPR2L; NPRL2; TUSC4
UniProt ID: (Human) Q8WTW4, (Mouse) Q9WUE4
Entrez Gene ID: (Human) 10641, (Mouse) 56032, (Rat) 363138